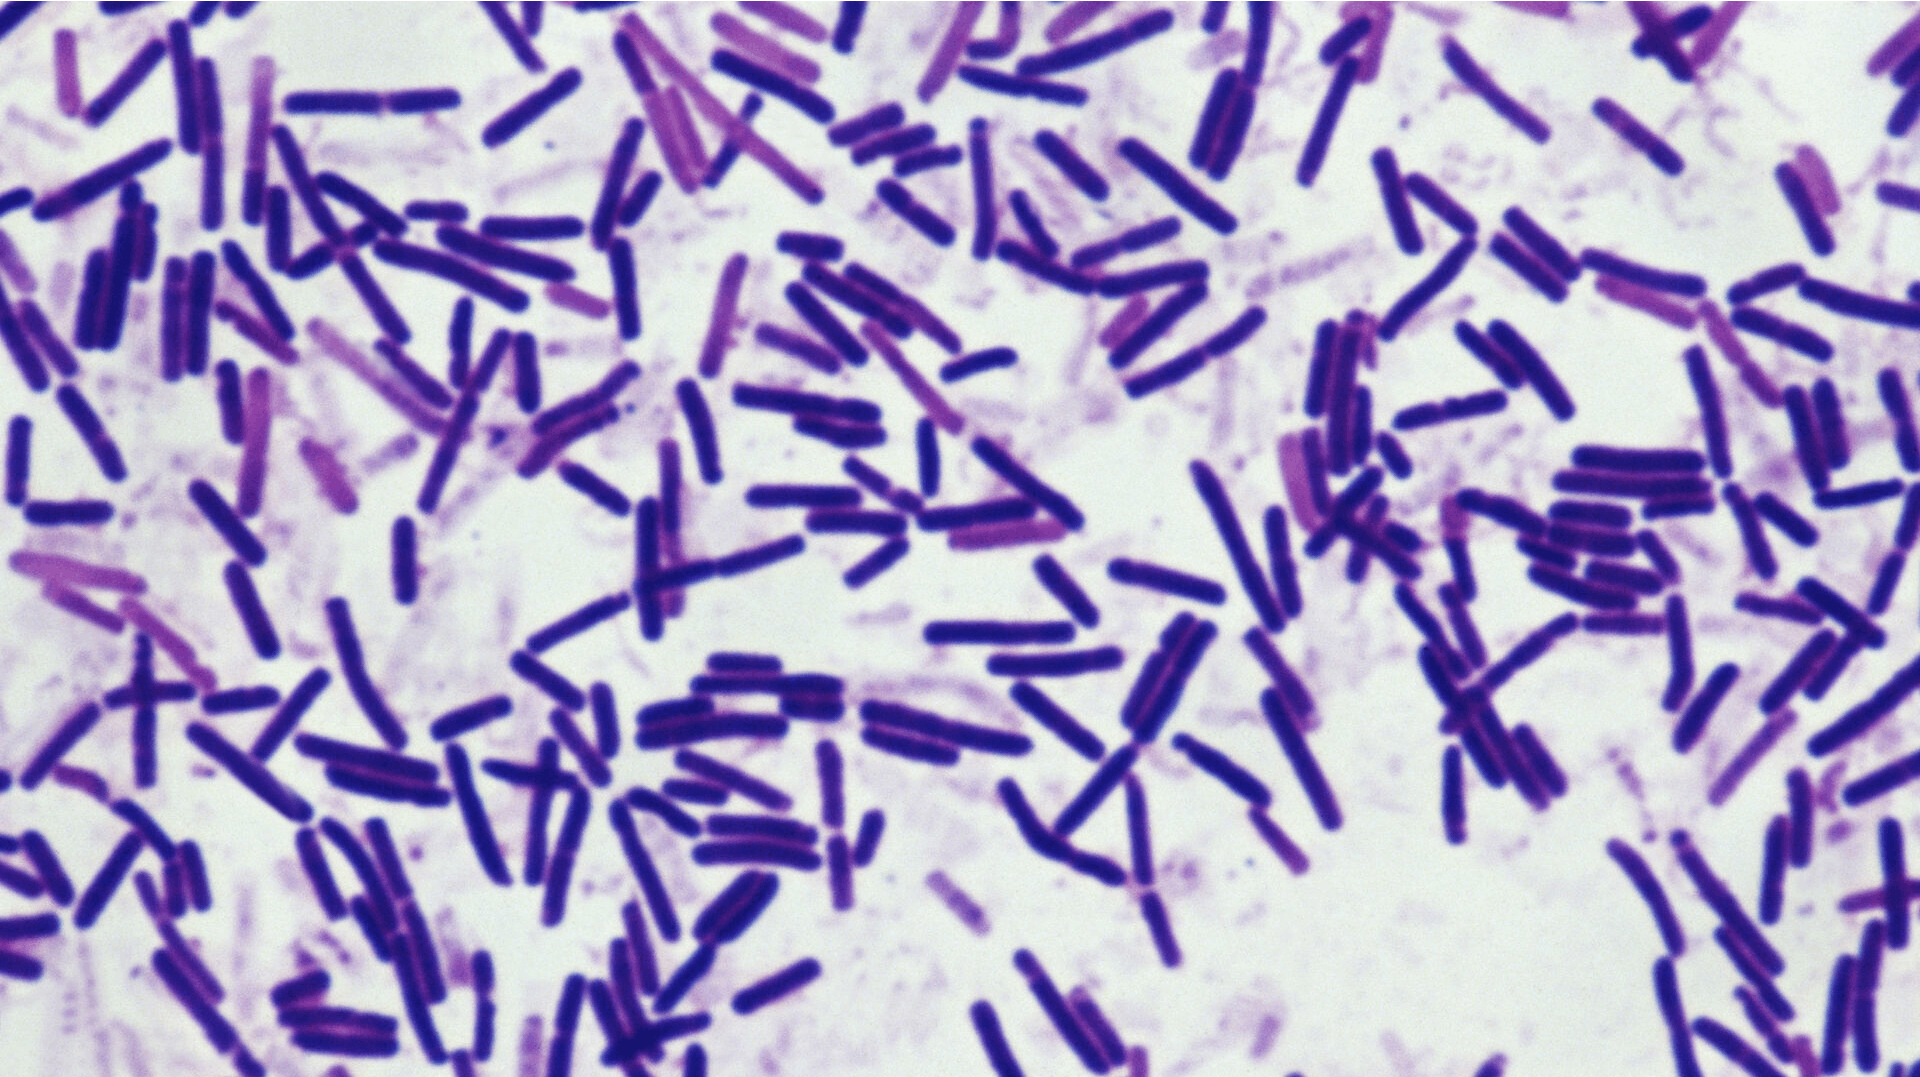

Turist død af uhyggelig lidelse: Havde spist sardiner
Gæster, der har spist på en særlig vinbar i Bordeaux, rådes lige nu til at opsøge læge straks.
Det sker, efter at en kvinde er død efter at have spist på vinbaren.
Det skriver Mirror.
Kvinden havde ifølge mediet spist sardiner fra dåse på den såkaldte Tchin Tchin Wine Bar i Bordeaux. Efterfølgende blev hun ramt af botulisme – også kaldt pølseforgiftning – og døde.
Foruden kvinden er 12 andre personer, der spiste på restauranten, blevet syge.
De er dog i behandling og ventes at komme sig. Der er ifølge Mirror tale om personer fra USA, Irland og Canada. Også en tysker og en spansk mand er blevet syge efter at have spist på stedet. De har modtaget behandling, efter de er kommet hjem til deres eget hjemland.
Fakta
Botulisme kaldes også pølseforgiftning og forekommer oftest i hjemmekonserverede fødevarer, der har været forurenet med jord. Her kan en jordbakterie kaldet Clostridium botulinum formuere sig og producere et giftstof kaldet botulinum.
Giftstoffet medfører lammelser, fordi det blokerer et signalstof mellem nerver og muskler. De fleste tilfælde er kortvarige og med milde symptomer, der går over af sig selv. Ved de sjældne, alvorlige forgiftninger lammes alle muskler gradvist - når vejrtrækningsmusklerne rammes, dør man af kvælning.